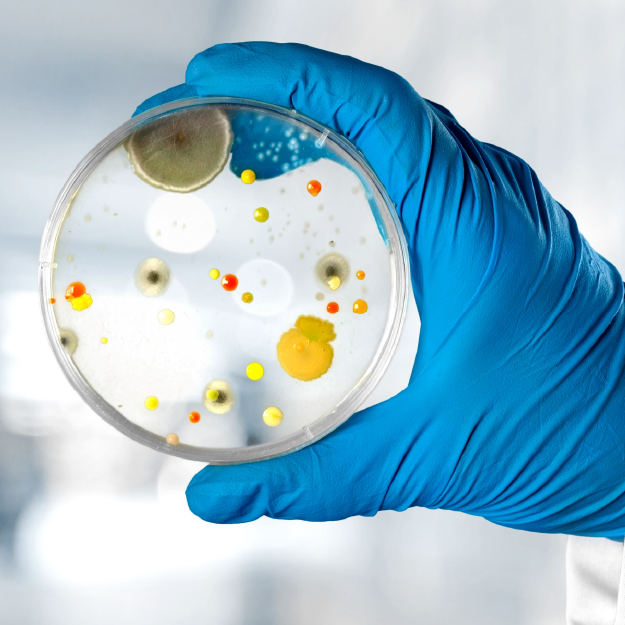
null

Suppliers of Laboratory Equipment, Laboratory Consumables & Clinical Consumables
Our focus is on reliability, quality, and long-term partnerships that support healthcare excellence and scientific advancement.
Welcome to Optaqon Medical Solutions
Our Brands
Our Products
Request For Quote
Add your items to cart and request for quotation
Receive Quote
Our team will respond with the quotation listing the items and prices
Make Payment
Make payments via EFT, cash or on our website
Wait for Delivery
Once payment is confirmed, wait for delivery of your items